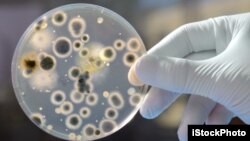
Researchers say many people believe antibiotics are effective against viral infections.

The World Health Organization says an increasing number of infections cannot be treated because of growing resistance to antibiotic drugs. This resistance puts the lives of millions of people at risk.
The WHO studied 133 countries. It found that no part of the world is ready to fight the growing threat. It says only twenty-five percent of the countries it studied has a thorough plan to fight resistance to antibiotics and other antimicrobial medicines.
The study also found that many people do not know about the problem. And, the researchers say many people believe antibiotics are effective against viral infections. The organization says this misunderstanding causes antibiotics to be used even when they will not work. The resulting overuse can cause resistance.
Charles Penn is a WHO expert on antimicrobial resistance. He says researchers discovered that antibiotics and similar medicines are sold in many places without a doctor’s prescription. He says this increases the possibility of overuse of antibiotics and increases resistance.
The WHO official says urgent action is needed or the world will enter a “post-antibiotic” period. That means a time when common infections and minor injuries could once again kill people. Charles Penn says doctors also would lose the ability to treat many more serious conditions like tuberculosis, HIV and malaria. And he says advanced medical treatments like major surgery will become much riskier or impossible.
This is not a problem for future worry. Charles Penn says there are diseases and infections that no longer are treatable with available antibiotics today. For example, he says antibiotics no longer affect the disease gonorrhea.
“Another example would be hundreds of thousands of new cases of multi-drug-resistant tuberculosis each year. Again, these are infections that have already become very difficult to treat. And it's difficult to put a precise number on what will happen in the future, but if we do not act it can only get worse.”
The World Health Assembly is now meeting in Geneva to discuss a Global Action Plan to fight antimicrobial and antibiotic resistance.
I’m Marsha James.
Correspondent Lisa Schlein reported this story from Geneva. Christopher Jones-Cruise adapted it into VOA Learning English. Caty Weaver was the editor.
_____________________________________________________________
Words in This Story
thorough – adj. including every possible part or detail
antimicrobial – adj. destroying or slowing the growth of microorganisms
prescription – n. a written message from a doctor that officially tells someone to use a medicine or therapy
surgery – n. medical treatment in which a doctor cuts into someone's body in order to repair or remove damaged or diseased parts
precise – adj. exact
Do people in your country suffer from infections and diseases that are resistant to antibiotics? We want to hear from you. Write your thoughts in the comments section.